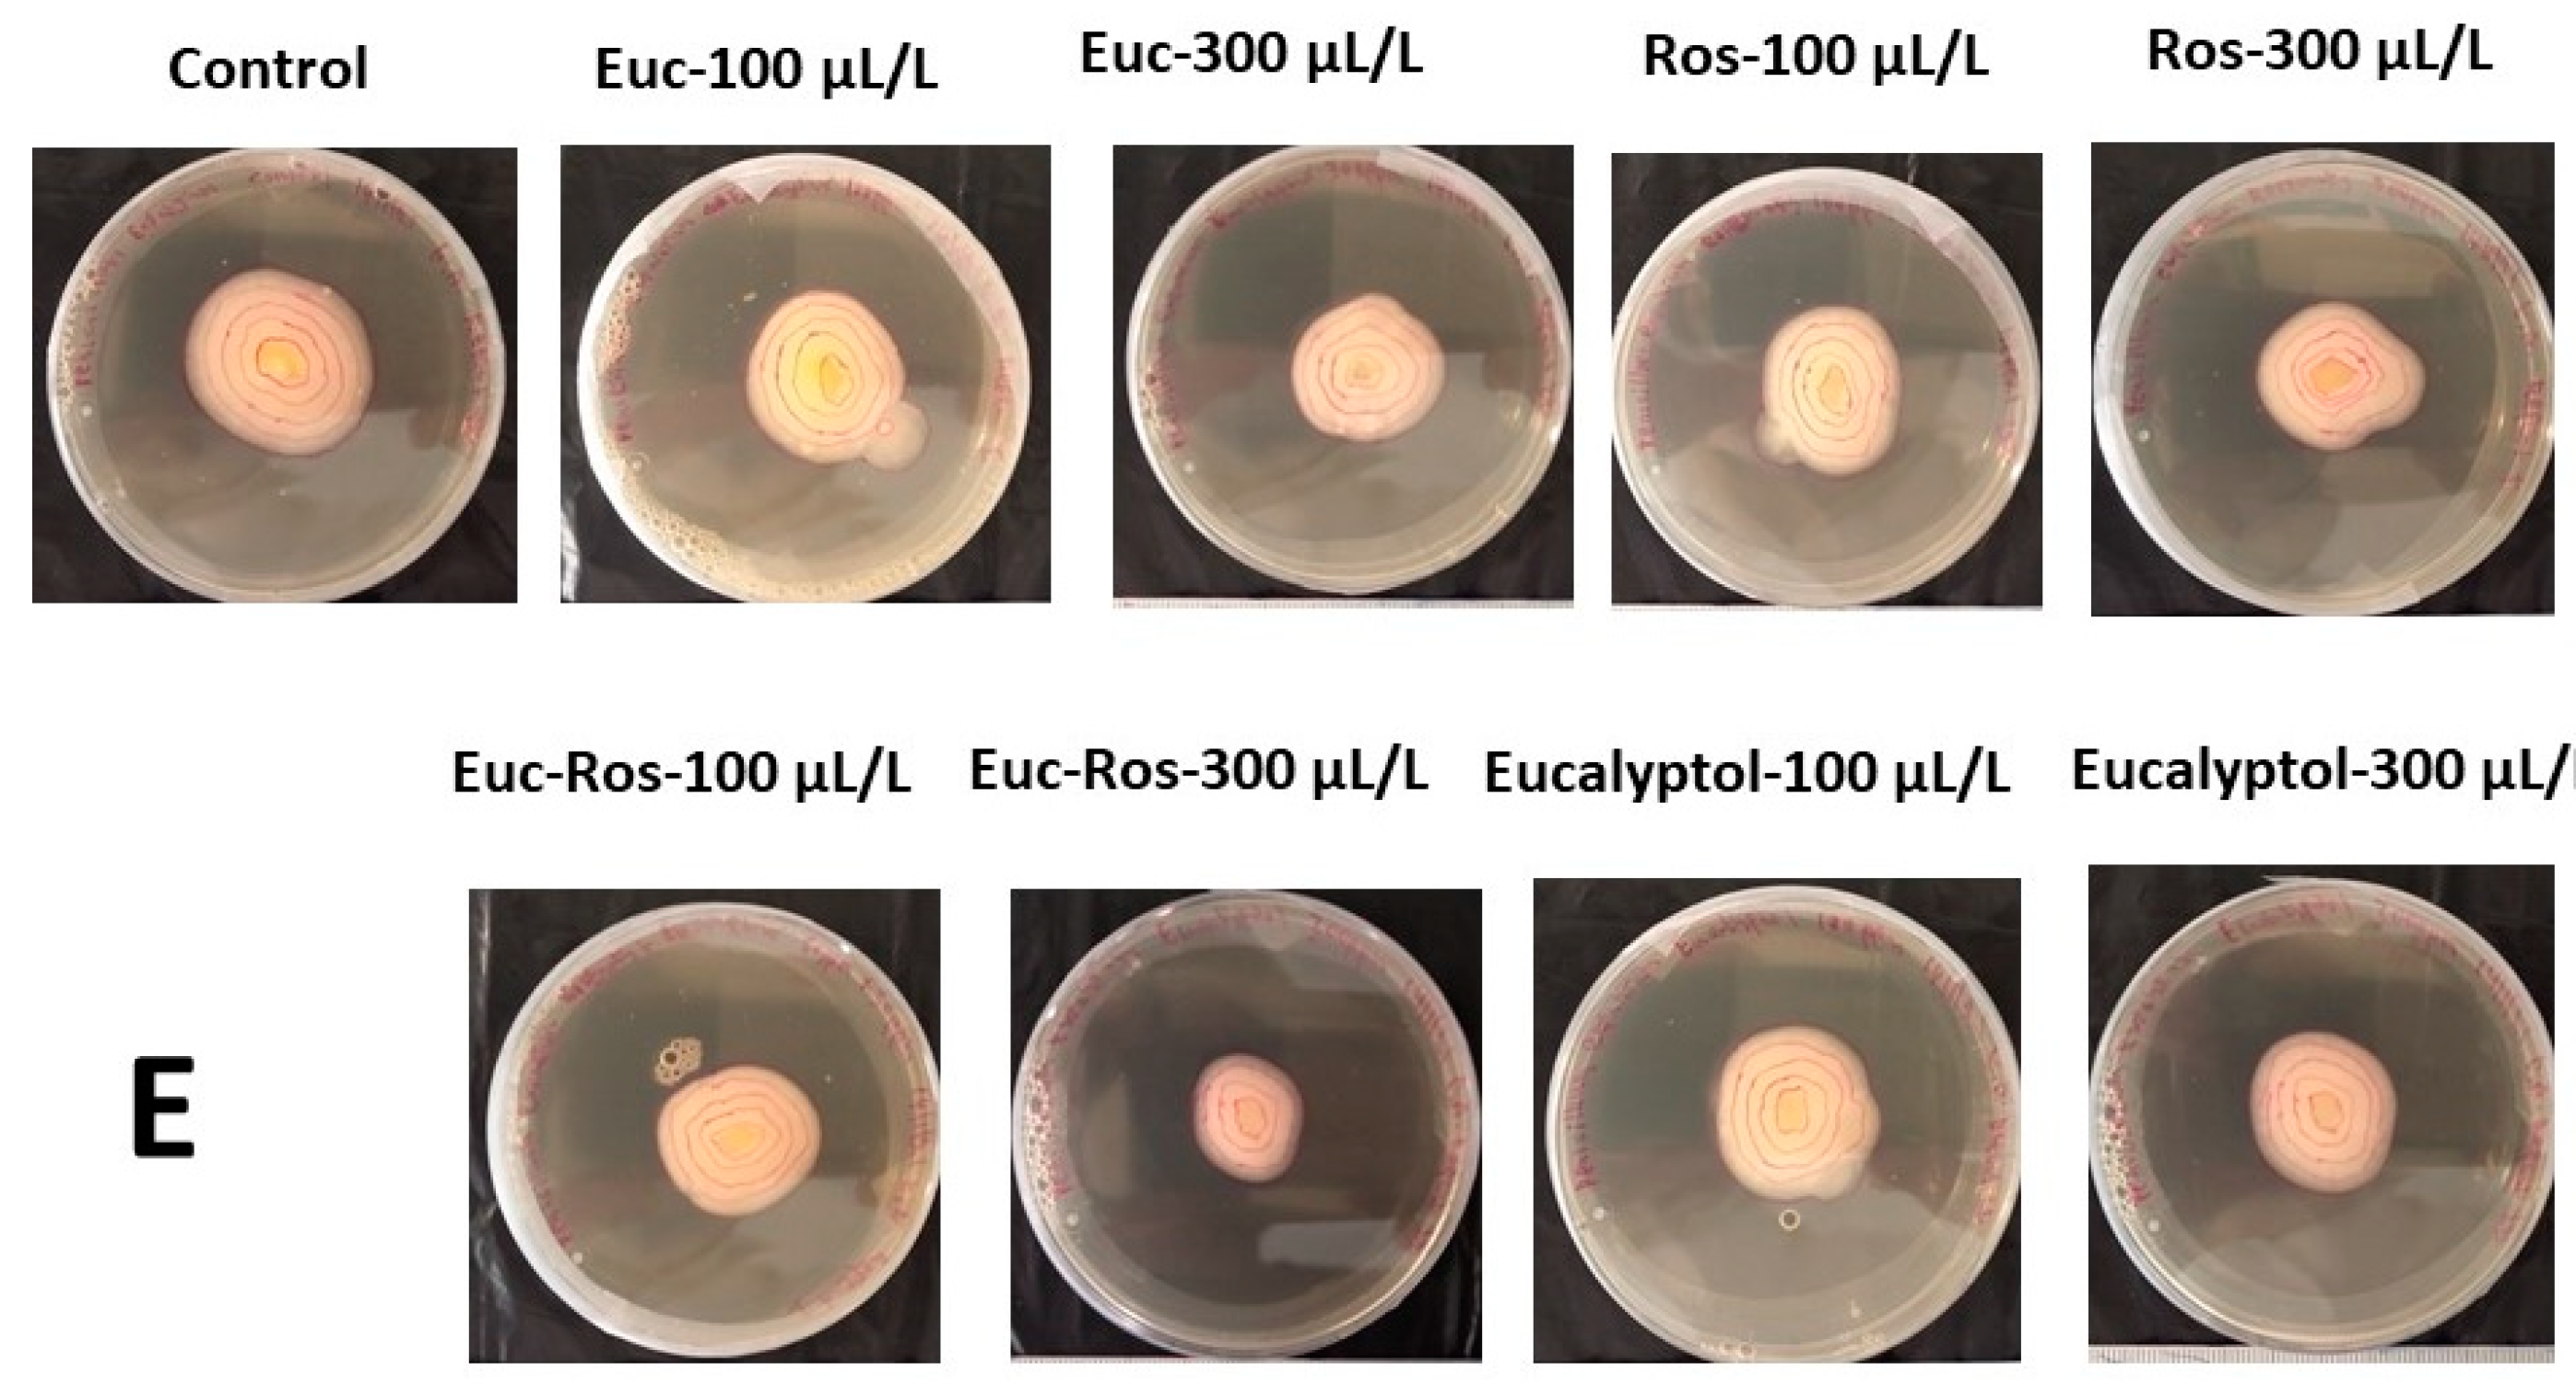
Horticulturae 07 00479 g001b

Application of Rosemary and Eucalyptus Essential Oils and Their Main Component on the Preservation of Apple and Pear Fruits
Abstract
:1. Introduction
2. Materials and Methods
2.1. Plant Material and Inoculum Preparation
2.2. In Vitro Evaluation of the EOs
2.3. In Vivo Evaluation of the EOs
2.3.1. Fruit Preparation and Inoculation
2.3.2. Lesion Growth
2.3.3. Effects on Fruit Quality Attributes
2.3.4. Determination of Damage Index
2.3.5. Sensory Evaluation
2.4. Statistical Analysis
3. Results
3.1. In Vitro
3.1.1. Effects on Colony Growth
3.1.2. Effects on Spore Production and Spore Germination
3.2. In Vivo
3.2.1. Effects on Lesion Growth
3.2.2. Effects on Fruit Quality Attributes
3.2.3. Damage Index (Hydrogen Peroxide and Lipid Peroxidation)
4. Discussion
5. Conclusions
Author Contributions
Funding
Institutional Review Board Statement
Informed Consent Statement
Acknowledgments
Conflicts of Interest
References
- Slavin, J.L.; Lloyd, B. Health Benefits of Fruits and Vegetables 1. Adv. Nutr. 2012, 3, 506–516. [Google Scholar] [CrossRef] [PubMed] [Green Version]
- Del Río-Celestino, M.; Font, R. The health benefits of fruits and vegetables. Foods 2020, 9, 369. [Google Scholar] [CrossRef] [Green Version]
- Klein, J.D.; Lurie, S. Prestorage Heating of Apple Fruit for Enhanced Postharvest Quality: Interaction of Time and Temperature. HortScience 2019, 27, 326–328. [Google Scholar] [CrossRef] [Green Version]
- Saleh, M.A.; Zaied, N.S.; Maksoud, M.A.; Hafez, O.M. Application of Arabic Gum and Essential Oils as the Postharvest Treatments of Le Conte Pear Fruits during Cold Storage. Asian J. Agric. Hortic. Res. 2019, 3, 1–11. [Google Scholar] [CrossRef]
- Rabiei, V.; Shirzadeh, E.; Rabbiangourani, H.; Sharafi, Y. Effect of thyme and lavender essential oils on the qualitative and quantitative traits and storage life of apple “Jonagold” cultivar. J. Med. Plant Res. 2011, 5, 5522–5527. [Google Scholar]
- Shirzadeh, E.; Rabiei, V.; Sharafi, Y. Effect of calcium chloride (CaCl2) on postharvest quality of apple fruits. Afr. J. Agric. Res. 2011, 6, 5139–5143. [Google Scholar]
- Peralta-Ruiz, Y.; Grande-Tovar, C.D.; Navia Porras, D.P.; Sinning-Mangonez, A.; Delgado-Ospina, J.; González-Locarno, M.; Maza Pautt, Y.; Chaves-López, C. Packham’s triumph pears (Pyrus communis L.) post-harvest treatment during cold storage based on chitosan and rue essential oil. Molecules 2021, 26, 725. [Google Scholar] [CrossRef]
- Tzortzakis, N.; Borland, A.; Singleton, I.; Barnes, J. Impact of atmospheric ozone-enrichment on quality-related attributes of tomato fruit. Postharvest Biol. Technol. 2007, 45, 317–325. [Google Scholar] [CrossRef]
- Znini, M.; Cristofari, G.; Majidi, L.; Mazouz, H.; Tomi, P.; Paolini, J.; Costa, J. Antifungal activity of essential oil from Asteriscus graveolens against postharvest phytopathogenic fungi in apples. Nat. Prod. Commun. 2011, 6, 1763–1768. [Google Scholar] [CrossRef] [PubMed] [Green Version]
- Zhang, H.; Wang, L.; Dong, Y.; Jiang, S.; Zhang, H.; Zheng, X. Control of postharvest pear diseases using Rhodotorula glutinis and its effects on postharvest quality parameters. Int. J. Food Microbiol. 2008, 126, 167–171. [Google Scholar] [CrossRef]
- Hosseini, S.; Amini, J.; Saba, M.K.; Karimi, K.; Pertot, I. Preharvest and Postharvest Application of Garlic and Rosemary Essential Oils for Controlling Anthracnose and Quality Assessment of Strawberry Fruit During Cold Storage. Front. Microbiol. 2020, 11, 1855. [Google Scholar] [CrossRef] [PubMed]
- Frankova, A.; Smid, J.; Bernardos, A.; Finkousova, A.; Marsik, P.; Novotny, D.; Legarová, V.; Pulkrabek, J.; Kloucek, P. The antifungal activity of essential oils in combination with warm air flow against postharvest phytopathogenic fungi in apples. Food Control 2016, 68, 62–68. [Google Scholar] [CrossRef]
- Tzortzakis, N.; Chrysargyris, A.; Sivakumar, D.; Loulakakis, K. Vapour or dipping applications of methyl jasmonate, vinegar and sage oil for pepper fruit sanitation towards grey mould. Postharvest Biol. Technol. 2016, 118, 120–127. [Google Scholar] [CrossRef]
- Tzortzakis, N. Essential oil: Innovative tool to improve the preservation of fresh produce—A review. Fresh Prod. 2009, 3, 87–97. [Google Scholar]
- Combrinck, S.; Regnier, T.; Kamatou, G.P.P. In vitro activity of eighteen essential oils and some major components against common postharvest fungal pathogens of fruit. Ind. Crops Prod. 2011, 33, 344–349. [Google Scholar] [CrossRef]
- Katooli, N.; Maghsodlo, R.; Razavi, S.E. Evaluation of eucalyptus essential oil against some plant pathogenic fungi. J. Plant Breed. Crop Sci. 2011, 3, 41–43. [Google Scholar]
- Lopez-Reyes, J.G.; Spadaro, D.; Prelle, A.; Garibaldi, A.; Gullino, M.L. Efficacy of plant essential oils on postharvest control of rots caused by fungi on different stone fruits in vivo. J. Food Prot. 2013, 76, 631–639. [Google Scholar] [CrossRef]
- Vieira, A.M.F.D.; Steffens, C.A.; Argenta, L.C.; do Amarante, C.V.T.; Oster, A.H.; Casa, R.T.; Amarante, A.G.M.; Espíndola, B.P. Essential oils for the postharvest control of blue mold and quality of “Fuji” apples. Pesqui. Agropecu. Bras. 2018, 53, 547–556. [Google Scholar] [CrossRef]
- Mouatcho, J.C.; Tzortzakis, N.; Soundy, P.; Sivakumar, D. Bio-sanitation treatment using essential oils against E. coli O157:H7 on fresh lettuce. N. Z. J. Crop Hortic. Sci. 2017, 45, 165–174. [Google Scholar] [CrossRef]
- Bakkali, F.; Averbeck, S.; Averbeck, D.; Idaomar, M. Biological effects of essential oils—A review. Food Chem. Toxicol. 2008, 46, 446–475. [Google Scholar] [CrossRef]
- Morcia, C.; Malnati, M.; Terzi, V. In vitro antifungal activity of terpinen-4-ol, eugenol, carvone, 1,8-cineole (eucalyptol) and thymol against mycotoxigenic plant pathogens. Food Addit. Contam. Part A Chem. Anal. Control. Expo. Risk Assess. 2012, 29, 415–422. [Google Scholar]
- Tzortzakis, N.G. Maintaining postharvest quality of fresh produce with volatile compounds. Innov. Food Sci. Emerg. Technol. 2007, 8, 111–116. [Google Scholar] [CrossRef]
- Jhalegar, M.J.; Sharma, R.R.; Singh, D. In vitro and in vivo activity of essential oils against major postharvest pathogens of Kinnow (Citrus nobilis × C. deliciosa) mandarin. J. Food Sci. Technol. 2015, 52, 2229–2237. [Google Scholar] [CrossRef]
- Servili, A.; Feliziani, E.; Romanazzi, G. Exposure to volatiles of essential oils alone or under hypobaric treatment to control postharvest gray mold of table grapes. Postharvest Biol. Technol. 2017, 133, 36–40. [Google Scholar] [CrossRef]
- Chrysargyris, A.; Panayiotou, C.; Tzortzakis, N. Nitrogen and phosphorus levels affected plant growth, essential oil composition and antioxidant status of lavender plant (Lavandula angustifolia Mill.). Ind. Crops Prod. 2016, 83, 577–586. [Google Scholar] [CrossRef]
- Tzortzakis, N.G.; Economakis, C.D. Antifungal activity of lemongrass (Cympopogon citratus L.) essential oil against key postharvest pathogens. Innov. Food Sci. Emerg. Technol. 2007, 8, 253–258. [Google Scholar] [CrossRef]
- Tzortzakis, N. Physiological and proteomic approaches to address the active role of Botrytis cinerea inoculation in tomato postharvest ripening. Microorganisms 2019, 7, 681. [Google Scholar] [CrossRef] [PubMed] [Green Version]
- AOAC International. Official Methods of Analysis, 18th ed.; AOAC International: Gaithersburg, MD, USA, 2007. [Google Scholar]
- Loreto, F.; Velikova, V. Isoprene produced by leaves protects the photosynthetic apparatus against ozone damage, quenches ozone products, and reduces lipid peroxidation of cellular membranes. Plant Physiol. 2001, 127, 1781–1787. [Google Scholar] [CrossRef]
- Chrysargyris, A.; Michailidi, E.; Tzortzakis, N. Physiological and biochemical responses of Lavandula angustifolia to salinity under mineral foliar application. Front. Plant Sci. 2018, 9, 489. [Google Scholar] [CrossRef] [Green Version]
- Stavropoulou, A.; Loulakakis, K.; Magan, N.; Tzortzakis, N. Origanum dictamnus Oil Vapour Suppresses the Development of Grey Mould in Eggplant Fruit in Vitro. BioMed Res. Int. 2014, 2014, 562679. [Google Scholar] [CrossRef] [Green Version]
- Aguilar-González, A.E.; Palou, E.; López-Malo, A. Antifungal activity of essential oils of clove (Syzygium aromaticum) and/or mustard (Brassica nigra) in vapor phase against gray mold (Botrytis cinerea) in strawberries. Innov. Food Sci. Emerg. Technol. 2015, 32, 181–185. [Google Scholar] [CrossRef]
- Bassolé, I.H.N.; Juliani, H.R. Essential oils in combination and their antimicrobial properties. Molecules 2012, 17, 3989–4006. [Google Scholar] [CrossRef] [Green Version]
- Soković, M.; Van Griensven, L.J.L.D. Antimicrobial activity of essential oils and their components against the three major pathogens of the cultivated button mushroom, Agaricus bisporus. Eur. J. Plant Pathol. 2006, 116, 211–224. [Google Scholar] [CrossRef]
- Mokbel, A.A.; Alharbi, A.A. Antifungal effects of basil and camphor essential oils against Aspergillus flavus and A. parasiticus. Aust. J. Crop Sci. 2015, 9, 532–537. [Google Scholar]
- da Silva, A.C.R.; Lopes, P.M.; de Azevedo, M.M.B.; Costa, D.C.M.; Alviano, C.S.; Alviano, D.S. Biological Activities of α-Pinene and β-Pinene Enantiomers. Molecules 2012, 17, 6305–6316. [Google Scholar] [CrossRef] [Green Version]
- Soković, M.D.; Brkić, D.D.; Džamić, A.M.; Ristić, M.S.; Marin, P.D. Chemical composition and antifungal activity of Salvia desoleana Atzei & Picci essential oil and its major components. Flavour Fragr. J. 2009, 24, 83–87. [Google Scholar]
- Javed, S.; Shoaib, A.; Mahmood, Z.; Mushtaq, S.; Iftikhar, S. Analysis of phytochemical constituents of Eucalyptus citriodora L. responsible for antifungal activity against post-harvest fungi. Nat. Prod. Res. 2012, 26, 1732–1736. [Google Scholar] [CrossRef]
- Shahi, S.K.; Patra, M.; Shukla, A.C.; Dikshit, A. Use of essential oil as botanical-pesticide against post harvest spoilage in Malus pumilo fruits. BioControl 2003, 48, 223–232. [Google Scholar] [CrossRef]
- Hyldgaard, M.; Mygind, T.; Meyer, R.L.; Debabov, D. Essential oils in food preservation: Mode of action, synergies, and interactions with food matrix components. Front. Microbiol. 2012, 3, 12. [Google Scholar] [CrossRef] [Green Version]
- Calvo, G.; Sozzi, G.O. Improvement of postharvest storage quality of “Red Clapp’s” pears by treatment with 1-methylcyclopropene at low temperature. J. Hortic. Sci. Biotechnol. 2004, 79, 930–934. [Google Scholar] [CrossRef]
- González, L.A.; Torres, F.; Quiñones, W. Changes in Tomato Metabolism by Applying 1,8-Cineole. J. Microb. Biochem. Technol. 2015, 7. [Google Scholar] [CrossRef] [Green Version]
- Bobelyn, E.; Serban, A.S.; Nicu, M.; Lammertyn, J.; Nicolai, B.M.; Saeys, W. Postharvest quality of apple predicted by NIR-spectroscopy: Study of the effect of biological variability on spectra and model performance. Postharvest Biol. Technol. 2010, 55, 133–143. [Google Scholar] [CrossRef]
- Gago, C.; Antão, R.; Dores, C.; Guerreiro, A.; Miguel, M.G.; Faleiro, M.L.; Figueiredo, A.C.; Antunes, M.D. The effect of nanocoatings enriched with essential oils on “Rocha” pear long storage. Foods 2020, 9, 240. [Google Scholar] [CrossRef] [PubMed] [Green Version]
- Larrigaudiere, C.; Lentheric, I.; Pintó, E.; Vendrell, M. Short-term effects of air and controlled atmosphere storage on antioxidant metabolism in conference pears. J. Plant Physiol. 2001, 158, 1015–1022. [Google Scholar] [CrossRef]
- Lu, X.; Ma, Y.; Liu, X. Effects of hydrogen peroxide accumulation, lipid peroxidation, and polyphenol oxidation during superficial scald development in ‘Fuji’ apples. Hortic. Environ. Biotechnol. 2014, 55, 299–307. [Google Scholar] [CrossRef]

| Respiration (mL CO2/kg/h) | Firmness (N) | TSS (°Brix) | TA (g malic acid/L) | TSS/TA Ratio | AA (g/100 g) | |||||||
|---|---|---|---|---|---|---|---|---|---|---|---|---|
| Treatment | 0 | 15 | 0 | 15 | 0 | 15 | 0 | 15 | 0 | 15 | 0 | 15 |
| Control | 7.79 ± 0.24 A | 4.79 ± 0.31 cB | 19.84 ± 0.63 A | 18.40 ± 1.14 abA | 10.63 ± 0.35 A | 8.53 ± 0.75 aA | 7.30 ± 0.25 A | 3.01 ± 0.14 aB | 1.46 ± 0.08 A | 2.82 ± 0.12 cA | 1.27 ± 0.01 A | 1.25 ± 0.70 aA |
| Euc-100 μL/L | 15.36 ± 0.39 b | 18.63 ± 0.95 ab | 8.43 ± 0.12 a | 1.85 ± 0.17 d | 4.64 ± 0.40 b | 1.06 ± 0.21 a | ||||||
| Euc-300 μL/L | 13.97 ± 1.50 b | 21.19 ± 1.33 a | 8.53 ± 0.27 a | 1.14 ± 0.13 e | 7.63 ± 0.72 a | 1.27 ± 0.01 a | ||||||
| Ros-100 μL/L | 5.15 ± 1.94 c | 18.69 ± 0.47 ab | 8.97 ± 0.22 a | 2.66 ± 0.08 ab | 3.38 ± 0.09 c | 1.27 ± 0.00 a | ||||||
| Ros-300 μL/L | 6.26 ± 0.71 c | 20.59 ± 0.59 ab | 8.30 ± 0.50 a | 2.53 ± 0.15 bc | 3.29 ± 0.17 c | 1.48 ± 0.21 a | ||||||
| Euc + Ros-100 μL/L | 7.48 ± 1.08 c | 21.24 ± 0.21 a | 9.00 ± 0.56 a | 3.05 ± 0.19 a | 3.00 ± 0.39 c | 1.27 ± 0.01 a | ||||||
| Euc + Ros-300 μL/L | 19.52 ± 1.88 a | 19.07 ± 0.91 ab | 8.43 ± 0.23 a | 2.19 ± 0.17 cd | 3.88 ± 0.24 bc | 1.27 ± 0.00 a | ||||||
| Eucalyptol-100 μL/L | 7.07 ± 0.24 c | 17.64 ± 1.57 b | 9.07 ± 0.37 a | 2.69 ± 0.15 ab | 3.37 ± 0.08 c | 1.48 ± 0.21 a | ||||||
| Eucalyptol-300 μL/L | 12.71 ± 0.88 b | 19.96 ± 1.34 ab | 8.17 ± 0.07 a | 0.98 ± 0.01 e | 8.36 ± 0.13 a | 1.50 ± 0.21 a | ||||||
| Respiration (mL CO2/kg/h) | Firmness (N) | TSS (oBrix) | TA (g malic acid/L) | TSS/TA Ratio | AA (g/100 g) | |||||||
|---|---|---|---|---|---|---|---|---|---|---|---|---|
| Treatment | 0 | 11 | 0 | 11 | 0 | 11 | 0 | 11 | 0 | 11 | 0 | 11 |
| Control | 17.82 ± 0.51 A | 12.25 ± 0.64 dB | 3.97 ± 0.13 A | 3.12 ± 0.64 aA | 12.47 ± 0.09 A | 10.07 ± 1.11 aA | 1.37 ± 0.01 A | 1.60 ± 0.17 aA | 9.10 ± 0.04 A | 6.28 ± 0.05 cB | 1.26 ± 0.01 A | 1.26 ± 0.01 abA |
| Euc-100 μL/L | 22.08 ± 1.44 ab | 4.09 ± 1.34 a | 8.47 ± 0.68 ab | 1.02 ± 0.11 bc | 8.52 ± 1.23 ab | 1.47 ± 0.19 a | ||||||
| Euc-300 μL/L | 17.77 ± 0.95 bc | 2.10 ± 0.25 a | 8.43 ± 0.59 ab | 0.66 ± 0.09 cd | 13.32 ± 2.16 bc | 1.26 ± 0.01 ab | ||||||
| Ros-100 μL/L | 15.71 ± 2.69 cd | 4.49 ± 0.65 a | 9.73 ± 0.23 a | 1.26 ± 0.04 ab | 7.74 ± 1.10 bc | 1.28 ± 0.00 ab | ||||||
| Ros-300 μL/L | 11.27 ± 2.35 d | 2.22 ± 0.94 a | 9.97 ± 0.20 a | 1.13 ± 0.10 b | 8.92 ± 0.77 bc | 1.26 ± 0.01 ab | ||||||
| Euc + Ros-100 μL/L | 26.85 ± 0.40 a | 2.86 ± 0.55 a | 9.13 ± 0.87 a | 0.93 ± 0.04 bc | 9.83 ± 0.62 bc | 1.03 ± 0.21 b | ||||||
| Euc + Ros-300 μL/L | 23.88 ± 0.16 a | 2.90 ± 0.14 a | 8.90 ± 0.12 a | 0.89 ± 0.16 bc | 10.61 ± 1.66 bc | 1.27 ± 0.00 ab | ||||||
| Eucalyptol-100 μL/L | 24.20 ± 0.38 a | 4.25 ± 1.06 a | 8.97 ± 0.43 a | 0.90 ± 0.18 bc | 11.14 ± 2.97 abc | 1.25 ± 0.01 ab | ||||||
| Eucalyptol-300 μL/L | 15.04 ± 2.23 cd | 2.03 ± 0.94 a | 6.97 ± 0.34 b | 0.46 ± 0.09 d | 16.26 ± 2.97 a | 1.47 ± 0.19 a | ||||||
| Apple | Pear | |||||
|---|---|---|---|---|---|---|
| Treatment | Aroma | Appearence | Marketability | Aroma | Appearence | Marketability |
| Control | 7.75 ± 0.25 a | 7.75 ± 0.28 a | 7.75 ± 0.28 a | 7.25 ± 0.25 ab | 7.50 ± 0.29 ab | 7.00 ± 0.41 ab |
| Euc-100 μL/L | 7.50 ± 0.28 a | 5.75 ± 0.25 c | 6.00 ± 0.00 bc | 7.50 ± 0.29 a | 3.50 ± 0.28 d | 3.25 ± 0.25 c |
| Euc-300 μL/L | 3.50 ± 0.29 c | 3.50 ± 0.29 d | 3.50 ± 0.29 d | 4.50 ± 0.29 d | 2.50 ± 0.29 e | 1.75 ± 0.25 d |
| Ros-100 μL/L | 7.50 ± 0.29 a | 7.50 ± 0.28 a | 7.50 ± 0.29 a | 7.50 ± 0.29 a | 7.50 ± 0.29 ab | 7.75 ± 0.25 a |
| Ros-300 μL/L | 7.25 ± 0.25 a | 7.50 ± 0.28 a | 7.25 ± 0.25 a | 7.25 ± 0.25 ab | 7.75 ± 0.25 a | 7.75 ± 0.25 a |
| Euc + Ros-100 μL/L | 7.00 ± 0.41 ab | 6.75 ± 0.25 ab | 6.75 ± 0.25 ab | 7.00 ± 0.41 abc | 7.00 ± 0.41 ab | 6.50 ± 0.29 b |
| Euc + Ros-300 μL/L | 6.25 ± 0.25 b | 6.00 ± 0.41 bc | 5.75 ± 0.25 c | 6.50 ± 0.29 bc | 6.75 ± 0.25 b | 6.75 ± 0.25 b |
| Eucalyptol-100 μL/L | 6.25 ± 0.25 b | 6.75 ± 0.25 ab | 6.75 ± 0.25 ab | 6.25 ± 0.25 c | 4.50 ± 0.29 c | 3.75 ± 0.25 c |
| Eucalyptol-300 μL/L | 3.25 ± 0.25 c | 1.25 ± 0.25 e | 1.25 ± 0.25 e | 3.20 ± 0.20 d | 1.00 ± 0.00 f | 1.00 ± 0.00 d |
| H2O2 (μmol/g) | MDA (nmol/g) | |||
|---|---|---|---|---|
| Treatment | 0 | 15 | 0 | 15 |
| Control | 0.04 ± 0.00 A | 0.03 ± 0.01 bA | 56.98 ± 0.92 A | 53.84 ± 1.36 deB |
| Euc-100 μL/L | 0.08 ± 0.00 ab | 75.40 ± 2.22 b | ||
| Euc-300 μL/L | 0.03 ± 0.01 b | 83.20 ± 2.78 a | ||
| Ros-100 μL/L | 0.04 ± 0.00 b | 59.02 ± 2.00 cde | ||
| Ros-300 μL/L | 0.05 ± 0.02 ab | 52.73 ± 0.88 e | ||
| Euc + Ros-100 μL/L | 0.04 ± 0.01 ab | 60.90 ± 1.98 c | ||
| Euc + Ros-300 μL/L | 0.10 ± 0.02 a | 59.65 ± 2.85 cd | ||
| Eucalyptol-100 μL/L | 0.04 ± 0.02 ab | 60.06 ± 1.71 cd | ||
| Eucalyptol-300 μL/L | 0.04 ± 0.01 b | 83.85 ± 2.87 a | ||
| H2O2 (μmol/g) | MDA (nmol/g) | |||
|---|---|---|---|---|
| Treatment | 0 | 11 | 0 | 11 |
| Control | 0.08 ± 0.01 A | 0.08 ± 0.01 bcA | 88.11 ± 2.26 A | 89.63 ± 2.57 deA |
| Euc-100 μL/L | 0.15 ± 0.02 a | 75.15 ± 0.95 f | ||
| Euc-300 μL/L | 0.09 ± 0.01 bc | 99.25 ± 4.27 cd | ||
| Ros-100 μL/L | 0.16 ± 0.02 a | 78.71 ± 2.18 ef | ||
| Ros-300 μL/L | 0.06 ± 0.01 c | 124.84 ± 1.51 a | ||
| Euc + Ros-100 μL/L | 0.09 ± 0.01 bc | 93.94 ± 2.81 cd | ||
| Euc + Ros-300 μL/L | 0.11 ± 0.01 b | 88.95 ± 4.06 de | ||
| Eucalyptol-100 μL/L | 0.09 ± 0.03 bc | 114.45 ± 2.91 ab | ||
| Eucalyptol-300 μL/L | 0.07 ± 0.00 bc | 104.64 ± 2.82 bc | ||
Publisher’s Note: MDPI stays neutral with regard to jurisdictional claims in published maps and institutional affiliations. |
© 2021 by the authors. Licensee MDPI, Basel, Switzerland. This article is an open access article distributed under the terms and conditions of the Creative Commons Attribution (CC BY) license (https://creativecommons.org/licenses/by/4.0/).
Share and Cite
Xylia, P.; Chrysargyris, A.; Ahmed, Z.F.R.; Tzortzakis, N. Application of Rosemary and Eucalyptus Essential Oils and Their Main Component on the Preservation of Apple and Pear Fruits. Horticulturae 2021, 7, 479. https://doi.org/10.3390/horticulturae7110479
Xylia P, Chrysargyris A, Ahmed ZFR, Tzortzakis N. Application of Rosemary and Eucalyptus Essential Oils and Their Main Component on the Preservation of Apple and Pear Fruits. Horticulturae. 2021; 7(11):479. https://doi.org/10.3390/horticulturae7110479
Chicago/Turabian StyleXylia, Panayiota, Antonios Chrysargyris, Zienab F. R. Ahmed, and Nikolaos Tzortzakis. 2021. "Application of Rosemary and Eucalyptus Essential Oils and Their Main Component on the Preservation of Apple and Pear Fruits" Horticulturae 7, no. 11: 479. https://doi.org/10.3390/horticulturae7110479
APA StyleXylia, P., Chrysargyris, A., Ahmed, Z. F. R., & Tzortzakis, N. (2021). Application of Rosemary and Eucalyptus Essential Oils and Their Main Component on the Preservation of Apple and Pear Fruits. Horticulturae, 7(11), 479. https://doi.org/10.3390/horticulturae7110479

